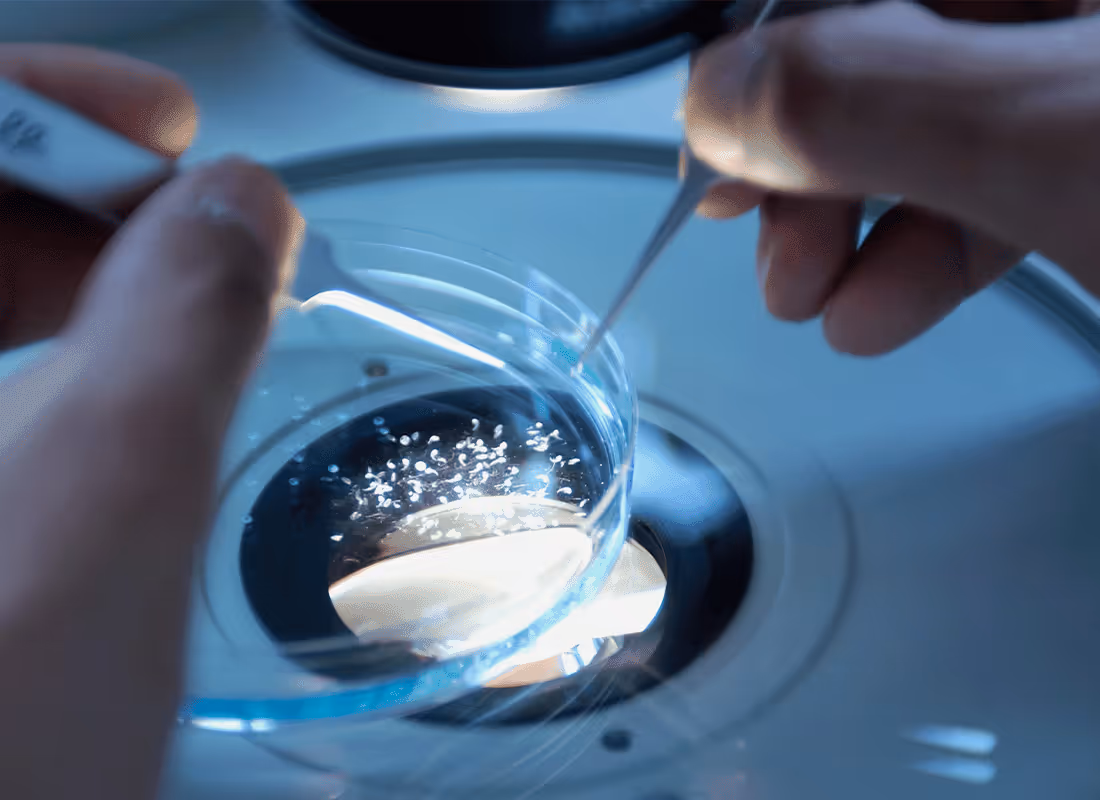

Backing the few

Backing the few who make the impossible possible.
Our Exited Companies
For us, success is measured by exits, when our companies either go public or get acquired. These events let us return capital to our investors and fund new, promising startups.
Success story
Our experiences prove that investing into breakthrough technologies requires patience. 14 years ago, we looked at Canatu's carbon nanotube technology and predicted wrap-around wrist screens. Today they're publicly traded, and their leading growth areas are pellicles and semiconductor filters.